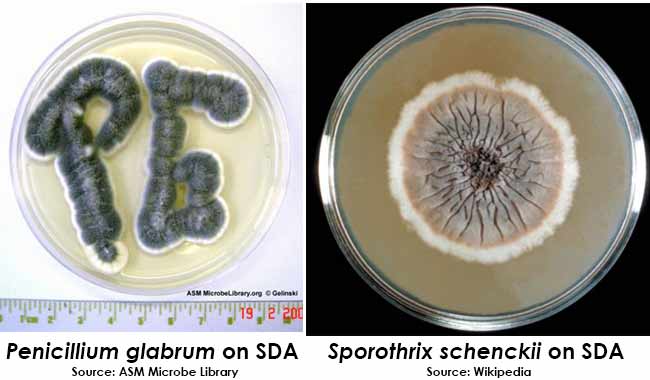

马铃薯葡萄糖琼脂(Potato Dextrose Agar)也称PDA培养基,是通用的霉菌和酵母选择性固体培养基。PDA培养基用于酵母和霉菌的检测、分离、计数和培养。
本品培养基组成成分:
|
成分
|
(g/L)
|
|
Potato Extract
|
4.0g
|
|
Dextrose
|
20.0g
|
|
Agar
|
15.0g
|
|
pH值
|
5.4-5.8
|
注意:
115℃高压灭菌20分钟备用。因为含有葡萄糖,不能用121℃灭菌,容易发生糖基化反应。
若所检样品细菌含量较低,则培养基无需添加Chloramphenicol;若所检样品细菌含量较高,
则倾注平板前每升培养基中需添加过滤除菌的Chloramphenicol 100mg。
PDA培养基实验结果与分析
|
(图 1:白假丝酵母) (图 2
|
:土发癣菌)
|
(图 3:光孢青霉) (图4
|
:申克孢子丝菌)
|


主要用于真菌培養
工作原理:
一般酵母菌和霉菌的营养需求较细菌低,可以在营养含量较低的培养基上生长。
另外,霉菌和酵母菌能够适应的pH范围较广,在pH3.4的条件下仍然能够增殖,
而绝大多数细菌则不能生长。
PDA培养基正是利用这两个特点来选择性分离和增菌霉菌和酵母。
向PDA培养基中加入酸稳定的抗细菌药物,如金霉素,可以进一步抑制细菌的生长。
科研常用培养基类別:
LB培养基:是微生物学实验中最常用的培养基,用于一般细菌培养,特别用于分子生物学试验中大肠杆菌的保存和培养。
用于培养大肠杆菌、枯草杆菌等细菌,分为液态培养基和加入琼脂制成的固态培养基。
加入抗生素的 LB 培养基可用于筛选以大肠杆菌为宿主的克隆。
PDA培养基:马铃薯葡萄糖琼脂培养基,即Potato Dextrose Agar (Medium)
依次对应马铃薯、葡萄糖、琼脂的英文。宜培养酵母菌、霉菌、蘑菇等真菌。
改良MC培养基:用于乳酸菌饮料中乳酸菌的菌落计数;
原理:大豆蛋白胨、牛肉膏粉和酵母膏粉提供氮源、维生素和生长因子;
葡萄糖和乳糖为可发酵糖类提供碳源;
乳酸菌发酵糖产酸使菌落周围碳酸钙溶解,以辨别乳酸菌;
琼脂是培养基的凝固剂;中性红为pH指示剂。
MRS培养基:乳酸菌培养基,由多种成分组成,适用于乳酸菌的生长,
用来分离培养乳酸菌的一类培养基,一种常用的培养基,宜培养分离乳酸菌。
由于该培养基十分适于乳酸菌的生长,而且抑制其他菌的生长,因此具有分离乳酸菌的功能。